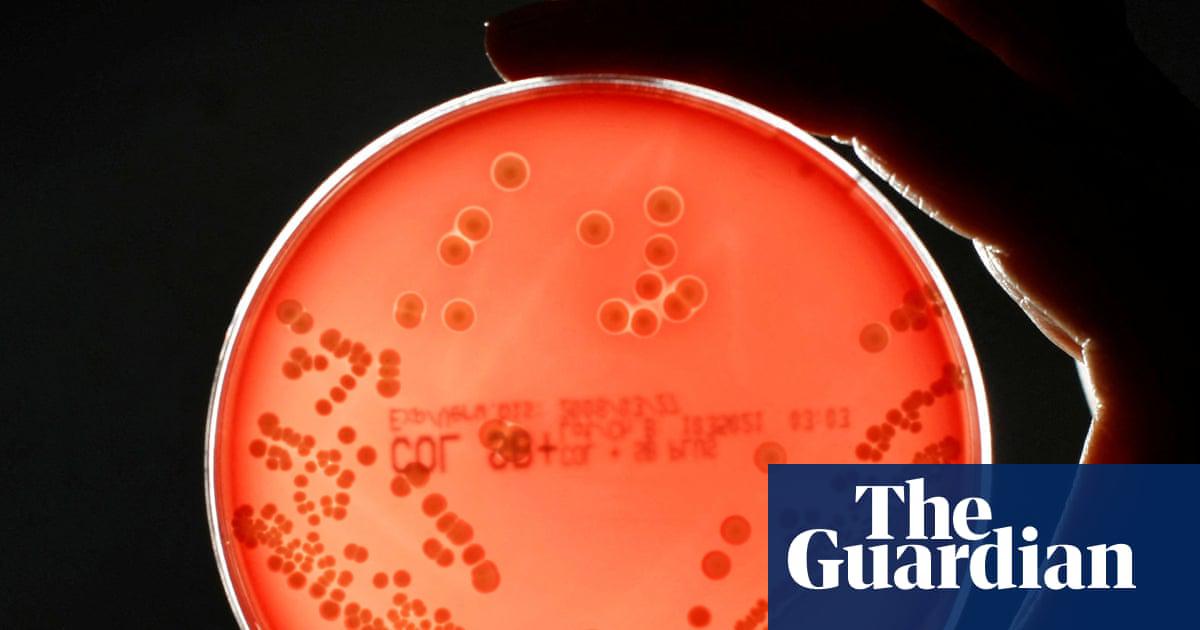

GUARDIAN | Business
Pipeline of new drugs to fight superbugs is ‘worryingly thin’, experts warn
对抗超级细菌的新药研发 pipeline “令人担忧地脆弱”,专家警告
The MRSA bacteria strain is an antibiotic-resistant superbug.
2026-03-10 447词 简单
“Overall, however, the R&D pipeline remains worryingly thin, and industry investment has lost momentum,” said Jayasree K Iyer, the chief executive of AMF. She described drug resistance as the biggest single threat to healthcare worldwide.
免责声明:本文来自网络公开资料,仅供学习交流,其观点和倾向不代表本站立场。